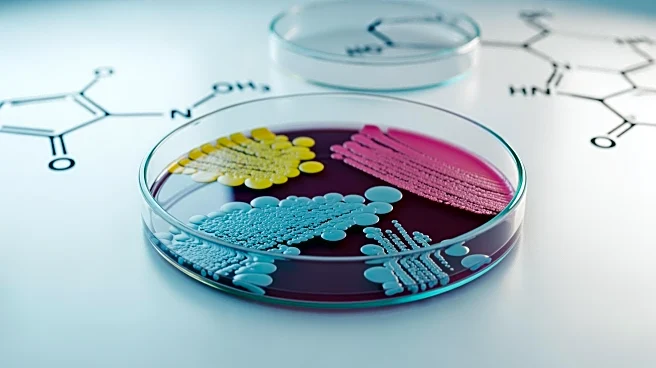
Study Links Glyphosate Exposure to Anxiety and Gut Microbiome Disruption

What's Happening?
Psychiatrist Joanna Cheek, in her book 'It’s Not You, It’s the World: A Mental Health Survival Guide for Us All,' emphasizes the health benefits of social interactions and collective care. Cheek argues that small social interactions, such as chatting
with a barista or a neighbor, can significantly contribute to a sense of community and personal well-being. She highlights research linking altruistic behavior and a sense of purpose with reduced inflammation, contrasting it with hedonistic pursuits that may increase inflammation. Cheek also discusses the concept of 'moral distress,' which signals the need for societal change in response to systemic issues like poverty and discrimination. Her approach suggests that fostering connections, even through brief interactions, can lead to broader societal improvements.
Why It's Important?
Cheek's insights underscore the importance of social connections in enhancing mental health and community cohesion. In a society where individualism often prevails, her emphasis on collective care challenges the notion that personal wellness can be achieved in isolation. This perspective is particularly relevant in addressing systemic issues, as it encourages individuals to engage in community-building activities that can lead to societal change. By promoting small acts of kindness and interaction, Cheek suggests that individuals can contribute to a more empathetic and connected society, potentially influencing public policy and social norms towards greater inclusivity and support.
What's Next?
The ideas presented by Cheek could inspire initiatives aimed at increasing social interactions within communities. This might involve creating more public spaces that encourage casual interactions or implementing community programs that foster inclusivity and support. Policymakers and community leaders may consider these insights when designing urban environments or social policies to enhance community well-being. Additionally, mental health professionals might integrate these concepts into therapeutic practices, encouraging patients to seek out social connections as part of their wellness routines.
Beyond the Headlines
Cheek's advocacy for social interactions as a form of self-care highlights a shift from traditional wellness practices focused solely on individual health. This approach could lead to a reevaluation of how mental health is addressed in both clinical and community settings. By recognizing the role of social connections in mental health, there may be a broader acceptance of community-based interventions as legitimate and effective methods for improving public health. This could also influence cultural attitudes towards mental health, reducing stigma and promoting a more holistic understanding of wellness.